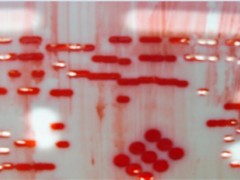

- 清洗回流焊后免洗锡膏残留物-合明科技PCBA清洗剂
- 2023-06-27浏览:441

- 线路板清洗后出现漏电和白斑现象分析-PCBA清洗剂合明科技
- 2023-06-27浏览:470

- 水基清洗剂-合明科技,为什么使用水基清洗剂是一种大方向?
- 2023-06-27浏览:331

- PCBA线路板焊接后残留物分析(一),合明科技
- 2023-06-27浏览:457

- PCBA线路板焊接后残留物分析(二)-合明科技
- 2023-06-27浏览:411

- 红胶清洗与红胶厚网有效清洗技巧介绍-红胶网板清洗剂
- 2023-06-27浏览:444
- 红胶网板清洗要怎么选择清洗剂?红胶网板清洗剂-合明科技
- 2023-06-27浏览:400

- 云南地坪涂料施工 环氧地坪漆 工业地坪施工 冠牌
- 2023-06-27浏览:320

- 合明科技与你分享:PCBA线路板清洗工艺(一)
- 2023-06-27浏览:343

- PCBA线路板加工污染有哪些?-线路板清洗合明科技
- 2023-06-27浏览:364

- 红胶网板清洗-合明科技攻克和解决国内外行业红胶网板清洗难题
- 2023-06-27浏览:407

- 重庆环氧聚硅氧烷漆冠牌批发
- 2023-06-25浏览:393

- SMC滤芯 AMG-EL850 AM-EL850
- 2023-06-21浏览:408

- 厂家生产SMC滤芯 AFF-EL850 AME-EL850
- 2023-06-21浏览:335

- SMC过滤器滤芯 AMD-EL550 AMG-EL550
- 2023-06-21浏览:451

- SMC滤芯 AMD-EL650 AME-EL650
- 2023-06-21浏览:343

- 进口滤材SMC滤芯 AFF-EL8B AMD-EL350
- 2023-06-21浏览:395

- 替代SMC滤芯AFF-EL850 AME-EL850
- 2023-06-21浏览:406

- 四川成都涂料施工-油漆工程施工-科冠经验丰富
- 2023-06-20浏览:395

- 四川成都镀锌件漆-镀锌件专用漆科冠供货
- 2023-06-20浏览:395